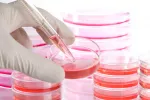
Pruebas de laboratorio para desarrollar organoides artificiales

Shinrin-yoku: baños de bosque para combatir el estrés

Los baños de bosque suelen prolongarse durante unas dos horas de caminata.
Actualizado: 5 de junio de 2024
¿Qué son los baños de bosque o shinrin-yoku?
En Japón, el país del karoshi o muerte por exceso de trabajo, una de las naciones con mayores tasas de suicidios del mundo, las autoridades sanitarias recomiendan desde los años ‘80 la práctica del shinrin-yoku, una actividad que tiene sus orígenes en las religiones budistas y sintoístas y cuyo significado literal es “absorber la atmósfera del bosque”. Es decir, bañarse metafóricamente en el bosque, conectando con la naturaleza y desconectando del estrés vital con el que convivimos cada día en un mundo, el occidental, cada vez más alejado de la naturaleza y más apegado a la tecnología y al asfalto de las ciudades.
Desde su origen, en un país en el que la naturaleza ocupa la mayor parte de su territorio (más del 60%), la Agencia Forestal japonesa ha habilitado a medio centenar de bosques con el sello de ‘centros de terapia forestal’, y la idea es llegar a los 100 durante la década de 2020. En ellos, cada año, se estima que entre 3 y 5 millones de japoneses (un porcentaje aún ínfimo de la población total nipona, que asciende a casi 130 millones) realizan cada año terapias de bosque.
Los dispositivos tecnológicos y los problemas del “mundo real” deben quedar fuera del shinrin-yoku para permitirnos centrar toda la atención en la experiencia
La práctica, como no podía ser de otra forma por sus características y beneficios, se ha globalizado y expandido especialmente por Estados Unidos, Canadá, el norte de Europa e incluso, de forma aún muy minoritaria, por algunos bosques y parques de España. Porque sí, aunque no es lo mismo y lo ideal es hacerlo en mitad de la naturaleza, en un gran parque urbano también podemos darnos nuestro particular baño de bosque, ya que un estudio publicado en Cities & Health en 2022 encontró que caminar por un parque urbano puede mejorar el estado de ánimo.
Cómo se practica el shinrin-yoku
Para llevar a cabo un baño de bosque es imprescindible, en primer lugar, la presencia de un monitor experto en la práctica, también conocidos como guías terapéuticos, cuya misión es calmarnos y hacernos bajar el ritmo con el que llegamos desde las ciudades para empezar a conectar con la naturaleza. Abrirnos la puerta al bosque, por así decirlo. Por supuesto también tenemos que poner de nuestra parte, así que la tecnología (ya sea en forma de smartphone o de dispositivos de audio) y los problemas del “mundo real” deben quedar fuera del shinrin-yoku para permitirnos centrar toda la atención en la experiencia.

Los baños de bosque suelen prolongarse durante unas dos horas de caminata, acompañadas de ejercicios de respiración y actividades dinamizadas por los monitores, que para promover la entrada en juego de los cinco sentidos pueden animarnos a respirar el aroma de un árbol, a sentir la suavidad del tacto de una flor, e incluso a tumbarnos sobre la hierba, cerrar los ojos, escuchar el sonido del aire o saborear un té, que en cierto modo es una forma de conectar con la naturaleza desde el sentido del gusto.
Beneficios para la salud de los baños de bosque
Se estima que desde 2004 el Gobierno de Japón ha invertido cerca de tres millones de euros para fomentar la investigación científica sobre los beneficios para la salud del shinrin-yoku. Según esos estudios, llevados a cabo por los investigadores Juyoung Lee y Yoshifumi Miyazaki, de la Universidad nipona de Chiba, y en los que han participado más de 600 personas, los baños de bosque tienen un impacto muy positivo entre quienes realizan la práctica de forma frecuente.
Concretamente, entre esos beneficios se encontrarían el descenso de casi el 6% en la media de infartos, el descenso de más del 12% de la hormona cortisol, relacionada directamente con el estrés, y el descenso en casi un punto y medio de media de la presión sanguínea de los participantes. De hecho, un estudio publicado en Scientific Reports en 2017 encontró que los bosques pueden tener un efecto positivo sobre la amígdala del cerebro y favorecer el manejo de los factores estresantes.
Además, otros estudios centrados más en aspectos neurobiológicos, han constatado también que estos baños de bosque disminuyen la actividad cerebral del córtex prefrontal, vinculado directamente con las funciones de planificación, toma de decisiones o resolución de problemas. Por ejemplo, un estudio publicado en Current Directions in Psychological Science en 2019 reveló que la exposición a entornos naturales potencia la memoria, la flexibilidad cognitiva y el control de la atención. Por el contrario, gracias al shinrin-yoku, la actividad cerebral de los participantes se desplaza principalmente a las áreas del cerebro relacionadas con las emociones, la empatía y el placer.
Hay menos evidencias científicas sobre cómo impactan los baños de bosque a los niños, pero un pequeño estudio publicado en 2023 por Tech Science mostró que los niños con alteraciones conductuales y problemas de salud mental experimentaron una reducción de la depresión, la ira y hostilidad, la fatiga y la confusión tras participar en un programa estructurado de baños de bosque, lo que sugiere que esta actividad también tiene ventajas para los más pequeños.
Por último, las investigaciones llevadas a cabo por el doctor Qing Li, profesor titular de la Escuela de Medicina de Tokio, también han mostrado el impacto positivo que los baños forestales tienen en el sistema inmunológico, al que fortalecen de cara a la lucha contra infecciones. Esto, según los resultados de los estudios, se debería a que los practicantes del shinrin-yoku verían aumentar de forma exponencial la presencia en sangre de un tipo de glóbulo blanco (células NK) conocido por sus propiedades protectoras frente a enfermedades. Empaparse de naturaleza parece sin duda una buena idea para tu salud.
Creado: 20 de noviembre de 2017